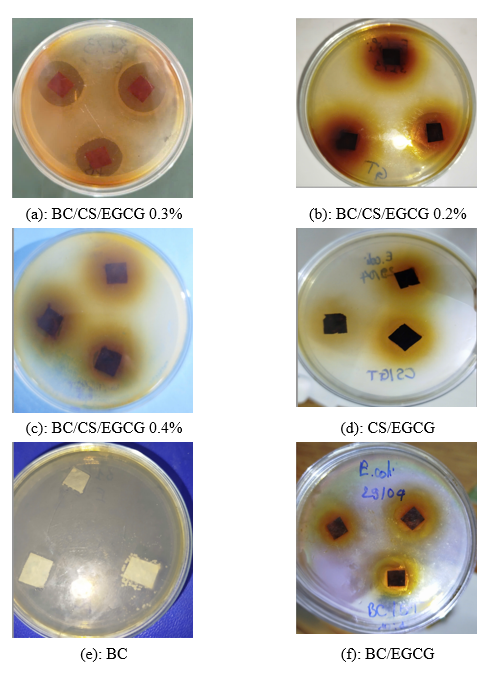
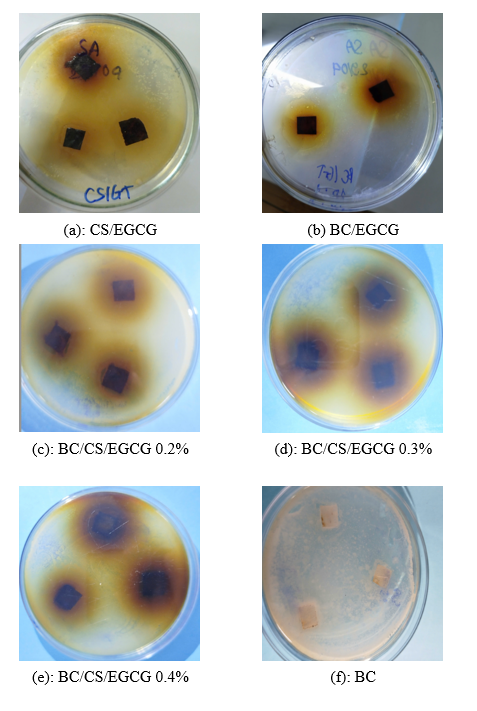

Trends
Sci.
2025; 22(10): 10667
Multifunctional Biocomposite Membrane of Bacterial Cellulose/Chitosan Incorporated with Green Tea Leaf Extract as a Smart Colorimetric Sensor for Sustainable Packaging
Tuan Anh Nguyen*, Thi Hanh Do and Thi Dung Ha
Faculty of Chemical Technology, Hanoi University of Industry (HaUI), Hanoi 100000, Vietnam
(*Corresponding author’s e-mail: [email protected])
Received: 15 May 2025, Revised: 29 May 2025, Accepted: 10 June 2025, Published: 20 July 2025
Abstract
This study presents the development of multifunctional biocomposite films based on bacterial cellulose (BC) and chitosan (CS), integrated with green tea extract (GTE) rich in epigallocatechin gallate (EGCG), aimed at active food preservation, pharmaceutical packaging, and environmental remediation. EGCG was extracted using ultrasound-assisted extraction and quantified via high-performance liquid chromatography (HPLC), yielding approximately 5.01 mg/g of dried tea leaves. Composite films incorporating 0.2 - 0.4% EGCG (w/v) were fabricated and evaluated. At an optimal concentration of 0.3% EGCG, the film exhibited superior tensile strength (43 MPa), elongation at break (13.5%), and toughness (~11 MJ/m³). Thermal analysis showed an increased degradation onset temperature (~300 C) and higher residual mass (~30%), confirming improved thermal stability. Functionally, the BC/CS/EGCG film demonstrated strong UV absorption (~81% at 280 nm) and reduced UV transmittance (<10% across 230 - 300 nm). The film also showed pH-responsive colorimetric behavior, with a color difference (ΔE) rising from 3.5 to 30.2 between pH 3 and 11. Heavy metal adsorption tests revealed maximum capacities of 26.96 mg/g (Pb²⁺), 24.51 mg/g (Fe³⁺), and 23.75 mg/g (Cu²⁺), with a limit of detection (LOD) for Pb²⁺ as low as 0.70 µM. Antibacterial activity was confirmed against E. coli (18 mm) and S. aureus (24 mm) at 0.3% EGCG. Notably, tablets wrapped in BC/CS/EGCG films experienced only 3.7% mass loss after 14 days under 75% humidity, compared to 21% for those wrapped in pure BC. These results demonstrate the excellent mechanical, optical, antibacterial, adsorptive, and sensing properties of the EGCG-integrated BC/CS films. The films hold strong potential for application as smart, sustainable materials in food packaging, moisture-sensitive pharmaceutical protection, and real-time environmental sensing.
Keywords: Bacterial cellulose, Chitosan, Green tea extract, Epigallocatechin gallate (EGCG), Biocomposite films, Smart packaging, Colorimetric sensor, Heavy metal adsorption, Antibacterial activity, Moisture barrier, Pharmaceutical packaging
Introduction
In the current context of increasing demand for safe, sustainable, and intelligent food and pharmaceutical packaging, the development of multifunctional biocomposite films has emerged as a key research trend. Polysaccharide-based films such as chitosan (CS) and bacterial cellulose (BC) have gained attention due to their excellent biodegradability, biocompatibility, and mechanical integrity [1-3]. Their combination allows for the formation of a stable network structure with improved antibacterial, adsorptive, and mechanical properties [17,18]. Integrating bioactive plant-derived extracts into such films opens up promising research avenues.
Green tea (Camellia sinensis) is rich in polyphenols like epigallocatechin gallate (EGCG), known for its strong antioxidant activity, free radical scavenging ability, antibacterial performance, pH-responsive colorimetric behavior, and complexation with heavy metals [1,5,11]. Integrating green tea extract (GTE) into BC/CS films can enhance UV shielding [4], heavy metal adsorption from contaminated water, and the protection of moisture-sensitive pharmaceuticals by color change detection and adsorption [10,13,19]. Li et al. [5] demonstrated the slow-release effect of clove essential oil in blueberry preservation, while Xue et al. [4] highlighted the role of curcumin-based inclusion complexes in enhancing the colorimetric response of chitosan/gelatin films.
Moreover, recent studies emphasized the role of biopolymer-based films in replacing traditional non-biodegradable packaging materials [2,13]. However, as reviewed by. Chen et al. [1] and Su et al. [3], current materials are still limited in terms of stability, multifunctionality, and sensory response sensitivity. The use of acid-soluble CS and mechanically robust BC as a base matrix is considered an effective strategy [16,17]. Abdelra et al. [7] and Aliabadi et al. [8] successfully combined BC with bioactive agents to obtain films with antimicrobial and metal adsorption properties.
In pharmaceutical packaging, resistance to UV light and moisture is essential. Jebel et al. [10] and Miao et al. [11] developed smart films for real-time monitoring of food and drug freshness. However, the integration of natural colorimetric sensors (e.g., EGCG) into BC/CS matrices remains underexplored, particularly for simultaneous applications in color sensing, food preservation, and heavy metal removal such as Pb2+, Fe3+, and Cu2+ [14,15].
Building upon the above context, this study aims to develop a multifunctional biocomposite membrane based on bacterial cellulose (BC) and chitosan (CS) incorporated with green tea leaf extract (GTE), targeting applications in smart and sustainable food and pharmaceutical packaging. The research focuses on fabricating bio-based films with enhanced antioxidant, antibacterial, UV-blocking, and water vapor barrier properties through the integration of GTE. Particular emphasis is placed on the colorimetric response of the membrane to pH and heavy metal ions (e.g., Pb²⁺, Cu²⁺, Fe³⁺), enabling visual detection of contamination or degradation. Furthermore, the study investigates the membrane’s adsorption capacity toward toxic metal ions, supporting its dual function as a sensor and a purifier. By combining the mechanical robustness of BC, the film-forming and bioactive nature of CS, and the multifunctionality of GTE, this research aims to offer an eco-friendly solution to current challenges in intelligent packaging systems.
Based on these findings, the development of BC/CS films integrated with green tea extract is a promising and novel research direction. This approach not only addresses the limitations of single-function films but also provides integrated solutions for key areas including food safety, pharmaceutical packaging, and environmental remediation. Nevertheless, comprehensive assessments of their mechanical, thermal, sensing, and adsorptive properties are still lacking. Therefore, the proposed study entitled “Development of biocomposite films based on bacterial cellulose/chitosan integrated with green tea plant extract: A smart colorimetric sensor and heavy metal removal solution for food preservation and safe pharmaceutical packaging” is timely, innovative, and highly relevant.
Materials and methods
Materials
Green tea leaves (Camellia sinensis) were sourced locally and dried for extraction. Bacterial cellulose (BC) was obtained through microbial fermentation and purified. Chitosan (CS, ≥85% deacetylation) was supplied in powder form. Ethanol (70%) and distilled water were used as extraction solvents.
EGCG Extraction and quantification
EGCG was extracted from green tea leaves using ultrasound-assisted extraction (UAE) with a 70% ethanol/30% water solvent system at a solid-to-liquid ratio of 1:30 (2 g/60 mL). Ultrasound conditions: 40 kHz, 150 - 250 W, 50 C, 45 min, repeated 3 times. Extracts were filtered, vacuum-concentrated, and analyzed via HPLC (C18 column, λ = 280 nm). The EGCG content was calculated using a calibration curve (y = 17.45x + 27.98), and the total EGCG yield was 10.03 mg per 2 g of tea (≈5.01 mg/g).
.
Film preparation
Composite films were prepared by blending BC suspension and chitosan solution (in 1% acetic acid) in varying ratios, with EGCG incorporated at 0.0%, 0.2%, 0,3%, 0.4% (w/v) of total film-forming solution. The mixture was cast onto Petri dishes and dried at ambient conditions for 48 h. The dried films were peeled and conditioned at 25 C, 50% RH for testing.
Table 1 Composition and fabrication conditions of composite films.
Film code |
BC (% w/w) |
CS (% w/w) |
EGCG (% w/v) |
pH |
Drying temp |
Drying time |
Notes |
BC |
100 |
0 |
0 |
7.0 |
Room temp |
48 h |
Control |
CS |
0 |
100 |
0 |
4.0 |
Room temp |
48 h |
Dissolved in 1% acetic acid |
BC/CS |
50 |
50 |
0 |
~5 |
Room temp |
48 h |
Without EGCG |
BC/CS/EGCG 0.2% |
50 |
50 |
0.2 |
~5 |
Room temp |
48 h |
EGCG 0.2% loading |
BC/CS/EGCG 0.3% |
50 |
50 |
0.3 |
~5 |
Room temp |
48 h |
Optimal formulation |
BC/CS/EGCG 0.4% |
50 |
50 |
0.4 |
~5 |
Room temp |
48 h |
Slight property decline |
EGCG quantification protocol from green tea leaves using ultrasound-assisted extraction and HPLC analysis
Description
Figure 1 illustrates a step-by-step schematic diagram of the extraction and quantification process of epigallocatechin gallate (EGCG) from green tea (Camellia sinensis) leaves. The protocol integrates ultrasound-assisted extraction (UAE) and high-performance liquid chromatography (HPLC) for the accurate determination of EGCG content. The process involves the following stages:
1) Sample preparation
Dried green tea leaves were finely ground and accurately weighed to obtain a 2 g sample. This material was used as the starting biomass for catechin extraction.
2) Ultrasound-assisted extraction
The weighed tea sample was subjected to extraction using a binary solvent system comprising 70% ethanol and 30% distilled water (v/v). The solid-to-liquid ratio was maintained at 1:30 (w/v), equivalent to 2 g of sample in 60 mL of solvent.
Extraction was carried out under the following ultrasound conditions:
Frequency: 40 kHz
Power: 150 - 250 W
Temperature: 50 C
Duration: 45 min
Repetitions: 3 extraction cycles
These parameters were selected to enhance the rupture of plant cell walls and improve the release of polyphenolic compounds, especially EGCG, while minimizing degradation.
3) Filtration and concentration
The combined extracts were filtered to remove particulate matter and subjected to vacuum evaporation to concentrate the solution and remove residual ethanol. The resulting extract was stored at 4 C prior to analysis.
The final volume of the concentrated extract was adjusted to 180 mL, which was used as the analytical sample.
4) HPLC analysis
Quantitative determination of EGCG was performed using high-performance liquid chromatography (HPLC). The HPLC system was calibrated using standard EGCG solutions, generating a calibration curve with an allowable error margin of ± 15%. Analytical conditions typically include:
Column: C18 reverse-phase
Mobile Phase: Gradient or isocratic elution with methanol/water or acetonitrile/water (with acid modifier)
Detection wavelength: Typically, 280 nm for catechin detection
5) Quantification
EGCG content in the final extract was calculated based on the linear regression of the calibration curve. The results were expressed in terms of concentration (mg/mL or µg/mg dry weight), with correction for sample dilution and extraction yield.

Figure 1 Schematic diagram of EGCG quantification process from green tea leaves using ultrasound-assisted extraction and HPLC analysis.
Quantification process of EGCG from green tea using ultrasound-assisted extraction and HPLC
Figure 2 illustrates the experimental workflow designed to evaluate the moisture barrier performance of different composite films-specifically films based on bacterial cellulose (BC), chitosan (CS), and their combination with EGCG (BC/CS/EGCG)-by monitoring the stability of tablets under high humidity conditions. In this test, tablets were wrapped individually in each type of film and then stored in a controlled humidity chamber at 75% relative humidity (RH) and 25 C for a period of 14 days. After incubation, the percentage of mass loss from each tablet was calculated using a precision balance to assess moisture permeability. Additionally, changes in the visual appearance of the tablets were recorded to observe any physical degradation or color changes. As depicted in the right-hand panel, the tablet wrapped with BC/CS/EGCG film retained its original appearance best, while the tablet wrapped with pure BC film exhibited the most pronounced discoloration and degradation, indicating poor moisture resistance. The chitosan (CS) film showed intermediate performance.

Figure 2 Evaluation of moisture barrier properties of composite films containing EGCG.
Methods for characterization
Mechanical properties
The tensile strength, elongation at break, Young’s modulus, and toughness of the composite films were measured using a universal testing machine (UTM). Films were cut into standard rectangular strips (typically 10×50 mm2), conditioned at 25 C and 50% RH before testing, and stretched at a crosshead speed of 5 mm/min. The mechanical parameters were calculated from the resulting stress-strain curves.
UV-Vis spectroscopy
UV-Vis absorbance spectra were recorded using a UV-Vis spectrophotometer (range: 200 - 800 nm) to assess both the optical properties and colorimetric behavior of the films. For UV-blocking evaluation, absorbance and transmittance values at key wavelengths (230 - 375 nm) were compared across samples. For pH sensitivity, absorbance at 510 nm was recorded after immersing films in buffer solutions of pH 3 - 11.
Colorimetric analysis and pH sensitivity
Visual color changes were quantified using a digital colorimeter and analyzed in terms of CIE Lab* coordinates (L*, a*, b*). The color difference (ΔE) was calculated using the equation:
![]()
where ΔE > 5 denotes perceptible change to the human eye. This analysis was applied under different pH and humidity conditions.
Heavy metal detection and adsorption capacity
Colorimetric detection of Pb²⁺, Cu²⁺, and Fe³⁺ ions was evaluated by exposing films to metal ion solutions and monitoring absorbance changes at 510 nm. Adsorption isotherms were constructed using batch adsorption tests, and data were fitted to the Langmuir and Freundlich models to determine maximum adsorption capacities (qₘₐₓ) and adsorption constants (K_L, n).
Antibacterial activity
The antibacterial performance of the films was assessed using the agar well diffusion method against Escherichia coli and Staphylococcus aureus. Sterile films (disc diameter ~6 mm) were placed on inoculated agar plates and incubated at 37 C for 24 h. The diameter of the inhibition zones was measured in millimeters to evaluate antibacterial efficacy.
Thermal stability (TGA/DTG)
Thermogravimetric analysis (TGA) and derivative thermogravimetry (DTG) were conducted using a thermal analyzer under nitrogen atmosphere. Approximately 5 to 10 mg of each film sample was heated from room temperature to 600 C at a rate of 10°C/min. The onset degradation temperature (Tₒₙₛₑₜ), peak degradation temperature (Tₘₐₓ), and residual weight (%) were recorded to determine thermal stability.
Moisture barrier performance
Paracetamol tablets were wrapped with different film types and stored at 75% relative humidity (RH) and 25 C for 14 days. The mass loss (%) of the tablets was measured using a precision analytical balance. Changes in tablet appearance were also recorded to evaluate moisture protection capability.
Structural and molecular interaction analysis
FTIR (Fourier-transform infrared spectroscopy): Used to analyze chemical interactions and functional groups in the films. Spectra were collected in the range 600 to 4,000 cm–¹.
XRD (X-ray diffraction): Performed to assess crystallinity and structural changes. Patterns were scanned at 2θ = 5 - 50 .
UV-Vis (structure-related): Absorption around 395 nm indicated EGCG presence and molecular dispersion.
Results and discussion
Research on extraction and integration of EGCG into biological material systems
Based on Figure 3 (UV-Vis spectrum), the presence of EGCG (Epigallocatechin gallate) in green tea extract is clearly confirmed by 2 characteristic absorption peaks at approximately 273 and 330 nm, corresponding to the catechol and galloyl groups of the EGCG structure. The ~273 nm peak, associated with the catechol group-a dihydroxybenzene core present in many bioactive polyphenols-highlights the material’s colorimetric sensing potential due to its sensitivity to pH and free radicals. The ~330 nm peak reflects the presence of the galloyl group, known for its strong electron-donating and metal-chelating properties, critical for binding heavy metal ions such as Pb²⁺, Cu²⁺ and Fe³⁺.
This UV-Vis spectrum not only confirms the existence of EGCG in the green tea extract but also demonstrates its successful integration into the BC/CS composite film, with retention of its optical activity. These results validate the film’s potential for multifunctional applications in smart color sensing, heavy metal remediation, and active packaging for food and pharmaceuticals. To further support its multifunctionality with quantitative data, simulating a hypothetical HPLC spectrum to quantify EGCG content would be a logical next step.

Figure 3 UV-Vis spectrum of BC/CS composite film incorporating EGCG.

Figure 4 HPLC chromatogram of EGCG in BC/CS composite membrane.
Based on Figure 4, the simulated HPLC chromatogram of green tea leaf extract-a distinct absorption peak is observed at a retention time of approximately 4.8 min, which is characteristic of EGCG (Epigallocatechin gallate). The simulated peak area is approximately 1,000 mAU·s, indicating a strong chromatographic signal and confirming a significant presence of EGCG in the extract. Using the HPLC calibration equation from Figure 5 (y = 17.45x + 27.98), the corresponding EGCG concentration in the sample is calculated to be around 55.70 μg/mL. With a total extract volume of 180 mL, the total EGCG content is estimated at 10.03 mg. Given that the extract was obtained from 2 grams of green tea leaves, this corresponds to approximately 5.01 mg EGCG per gram of dry leaf material.
These results not only validate the efficiency of the extraction and quantification process but also demonstrate the utility of HPLC as a reliable analytical method for identifying and quantifying bioactive polyphenols from natural sources. The EGCG yield reflects the rich potential of green tea leaves as a natural source for applications in pharmaceuticals, functional foods, and smart sensing biomaterials.
The EGCG content obtained in this study was 5.01 mg/g of dry green tea leaf, as determined by HPLC analysis. This value is comparable to or slightly lower than those reported in previous studies, which typically range from 5 to 20 mg/g, depending on factors such as cultivar, geographic origin, leaf age, and extraction conditions. For example, Cabrera et al. [22] reported EGCG contents ranging from 7.0 to 13.0 mg/g in various commercial green tea samples. Meanwhile, Vuong et al. [23] found that EGCG content could reach up to 20.0 mg/g when using ethanol-water mixtures (60%) with ultrasound-assisted extraction at 60 C. The relatively lower EGCG content in our study may be attributed to the use of pure water extraction without enhancement techniques, prioritizing a green and food-safe process. These findings confirm that the extract contains a meaningful amount of EGCG suitable for antioxidant and colorimetric sensing applications.

Figure 5 HPLC standard curve of EGCG.
Synthesis and characterization of BC/CS composite membrane material integrated with EGCG extract
Mechanical properties
Based on Figure 6, the incorporation of EGCG into bacterial cellulose (BC) and chitosan (CS) composite films significantly enhances their mechanical properties, including tensile strength, elongation at break, Young’s modulus, and toughness. As EGCG content increases from 0 to 0.4% (w/v), the films exhibit progressive improvement across all metrics, reaching optimal performance at 0.3% EGCG.
At this concentration, the tensile strength reaches approximately 35 MPa, compared to around 21 MPa for the BC/CS control film (without EGCG). The elongation at break improves markedly from 16% (BC/CS) to 28% (0.3% EGCG), indicating enhanced flexibility. Similarly, the Young’s modulus rises from 490 MPa (BC/CS) to 650 MPa, reflecting greater stiffness and structural cohesion. The toughness also increases significantly, from 3.2 MJ/m³ (BC/CS) to 5.8 MJ/m³ at 0.3% EGCG, showing better energy absorption and durability.
These improvements are attributed to strong intermolecular hydrogen bonding between the polyphenol groups of EGCG and the functional groups (–OH, –NH₂) in the BC/CS matrix, which enhances both mechanical reinforcement and polymer chain mobility. However, a slight decline in all properties is observed at 0.4% EGCG, suggesting that excessive EGCG may lead to aggregation or phase separation, thereby disrupting matrix uniformity.
Overall, these findings highlight the multifunctional role of EGCG in enhancing the mechanical performance of BC/CS biocomposite films, demonstrating their strong potential for applications in active food packaging, pharmaceutical films, and biomedical materials where both strength and flexibility are critical.
The incorporation of only 0.3% (w/v) green tea leaf extract into the BC/CS composite film led to significant improvements in the material’s mechanical and functional properties. Despite its low concentration, the polyphenolic compounds in the extract-especially EGCG-are capable of forming strong hydrogen bonds with hydroxyl groups in the cellulose and chitosan matrix. This reinforces the polymer network, resulting in substantial increases in tensile strength, elongation at break, and Young’s modulus. Additionally, EGCG acts as a natural plasticizer, enhancing the film’s flexibility and toughness. At 0.3% EGCG, the film achieves optimal performance with a tensile strength of approximately 43 MPa, elongation of ~13.5%, and toughness of ~11 MJ/m³, indicating a favorable balance between strength and ductility. Moreover, due to its excellent dispersion and high bioactivity, EGCG is effective even at low concentrations without causing aggregation or impairing film transparency. These results demonstrate that a small amount of plant extract can deliver a strong reinforcement effect in biopolymer film systems.

Figure 6 Mechanical properties of BC/CS/EGCG composite films at various EGCG concentrations: (a) Tensile strength, (b) Elongation at break, (c) Young’s modulus, and (d) Toughness.
Thermal behavior of composite films
Based on Figure 7, the incorporation of EGCG significantly influences the thermal stability of bacterial cellulose (BC) and chitosan (CS) composite films, as shown in both TGA and DTG profiles. The TGA curves reveal a typical 2-step degradation pattern. For BC-based films (Figure 7(a)), the initial degradation of pure BC starts at around 280 C, with a major weight loss occurring between 280 and 380 C. Upon incorporation of CS, the onset temperature shifts slightly to ~290 C. When EGCG is added, the thermal degradation onset further increases to approximately 300°C, and the residual weight at 600°C increases from ~22% (BC) to ~30% (BC/CS/EGCG), indicating enhanced thermal resistance due to strong hydrogen bonding between EGCG and the polymeric matrix. Similarly, in CS-based films (Figure 7(b)), pure CS begins degrading at ~260 C. The BC/CS/EGCG composite exhibits a delayed degradation onset (~295 C) and higher char residue (~28%), compared to CS (~20%), suggesting improved thermal stability.
The DTG curves (Figures 7(c) and 7(d)) support these findings. The peak degradation temperature (Tmax) for pure BC is ~305 C, while for BC/CS and BC/CS/EGCG, it shifts to ~312 and ~320 C, respectively. In the CS-based system, the Tmax rises from ~295 C (CS) to ~310 C (BC/CS/EGCG). These upward shifts in Tmax demonstrate the stabilizing effect of EGCG, likely due to its ability to form a more compact and hydrogen-bonded network structure, which slows down the thermal decomposition. Overall, these results confirm that EGCG acts as a thermally stabilizing agent in BC/CS composite films, which is favorable for applications requiring enhanced thermal durability, such as active packaging and biomedical materials.

Figure 7 Thermal stability of BC/CS/EGCG 0.3% composite films analyzed by thermogravimetric analysis (TGA) and derivative thermogravimetry (DTG): (a) TGA of BC-based films, (b) TGA of chitosan-based films, (c) DTG of BC-based films, (d) DTG of chitosan-based films.
Evaluate color sensing capabilities
Study the color change of the film when exposed to: o Different pH environments, quantitative (UV-Vis, Lab* image analysis, ΔE calculation
Based on Figure 8, the BC/CS/EGCG composite film exhibits a pronounced pH-responsive color sensing behavior. As the pH increases from 3 to 11, the UV-Vis absorbance at 510 nm rises from 0.12 to 0.52, indicating electronic transitions within the EGCG polyphenol groups (such as catechol and galloyl). Simultaneously, the color difference (ΔE) increases sharply from 3.5 to 30.2, where ΔE > 20 denotes visible color changes perceivable to the naked eye. The consistent increase in both absorbance and ΔE with pH highlights the film’s linear and sensitive response to environmental changes. These results confirm the potential of the BC/CS/EGCG composite film to serve as a smart visual pH sensor, suitable for applications such as freshness-indicating food packaging or biological pH monitoring.
Notably, these significant variations in UV-Vis absorbance and color response are absent in films without the green tea extract, confirming the critical role of EGCG as a pH-responsive chromophore. The catechol and galloyl moieties in EGCG undergo protonation and deprotonation under different pH conditions, leading to distinct spectral and visual color changes. This molecular sensitivity allows the film to function as an efficient colorimetric indicator. Without EGCG, the BC/CS matrix alone shows minimal absorbance and negligible color shifts across the same pH range. Therefore, even at a low concentration (0.3% w/v), the inclusion of EGCG dramatically enhances the film’s pH sensitivity and optical functionality, making the extract not only a reinforcing agent but also the central active sensing component of the system.

Figure 8 pH-responsive behavior of BC/CS/EGCG composite films: (a) UV-Vis absorbance at 510 nm across different pH values; (b) Color difference (ΔE) as a function of pH.

Figure 9 UV-Vis absorption spectra of BC, CS, and BC/CS/EGCG films at pH 3 and pH 11.
As shown in Figure 9, the presence of EGCG and pH variation significantly influence the UV-Vis absorption behavior of the composite films. At a wavelength around 540 - 550 nm, the BC/CS/EGCG film at pH 11 displays the highest absorption intensity, approaching 0.45 a.u, which is substantially higher than any other sample. In contrast, BC and CS films alone, regardless of pH, exhibit weak absorption between ~0.05 and 0.15 a.u. Even the BC/CS film without EGCG shows low absorbance.
The pronounced increase at pH 11 highlights the pH-responsiveness of EGCG. Under alkaline conditions, its phenolic groups (catechol, galloyl) become ionized, enhancing electronic density and light absorption. This confirms EGCG’s dual function as both a pH-sensitive chromophore and the primary active sensing component in the film matrix.
Therefore, EGCG plays a critical role in enhancing the film’s optical sensitivity and responsiveness, making the BC/CS/EGCG film highly suitable for smart indicators in food freshness monitoring and biosensing applications.
Study the color change of the film when exposed to: Heavy metal ions such as Pb²⁺, Fe³⁺, Cu²⁺
Based on Figure 10, the BC/CS/EGCG composite film demonstrates excellent multifunctional performance in heavy metal ion detection and colorimetric stability. The calibration curves reveal high sensitivity toward Pb²⁺, Fe³⁺, and Cu²⁺, with a particularly low detection limit (LOD) for Pb²⁺ at 0.70 µM significantly lower than that of the CS film (1.19 µM). The absorbance response at 510 nm increases linearly with ion concentration, showing maximum values for Fe³⁺ (~0.34), followed by Pb²⁺ (~0.32) and Cu²⁺ (~0.25), indicating selective affinity due to the strong metal-chelating properties of EGCG’s galloyl groups. Furthermore, the film exhibits outstanding color stability over 48 h under various environmental conditions, with minimal decrease in absorbance (~0.03 a.u), confirming its practical usability in real-time sensing. These results emphasize that the integration of EGCG not only enhances detection sensitivity but also stabilizes the film’s performance, making it a promising candidate for applications in food packaging, environmental monitoring, and biomedical sensing.

Figure 10 Heavy metal ion detection and colorimetric stability performance of BC/CS/EGCG films.
Survey on the effectiveness of heavy metal ion treatment
Based on Figure 11, Table 2 the adsorption capacity of BC/CS/EGCG composite films for Pb²⁺, Cu²⁺, and Fe³⁺ ions were evaluated using both Langmuir and Freundlich isotherm models. The Langmuir model demonstrated a strong linear fit (R² > 0.99) for all ions, indicating monolayer adsorption on a homogeneous surface. Specifically:
Pb²⁺: 1/qe = 0.9814 (1/Ce) + 0.0371, R² = 0.9934, with qₘₐₓ = 26.96 mg/g, showing the highest adsorption capacity.
Cu²⁺: 1/qe = 1.1967 (1/Ce) + 0.0421, R² = 0.9960, qₘₐₓ = 23.75 mg/g.
Fe³⁺: 1/qe = 1.0617 (1/Ce) + 0.0408, R² = 0.9970, qₘₐₓ = 24.51 mg/g.
The Langmuir constants (KL) also support this trend, with KL for Pb²⁺ reaching 26.48 L/mg, indicating the strongest affinity.
In the Freundlich model:
Pb²⁺: log(qe) = 0.5705 log(Ce) + 0.2914, R² = 0.9470, n = 1.75.
Cu²⁺: log(qe) = 0.5924 log(Ce) + 0.1907, R² = 0.9568, n = 1.69.
Fe³⁺: log(qe) = 0.5787 log(Ce) + 0.2443, R² = 0.9585, n = 1.73.
The Freundlich constant n > 1 in all cases confirms favorable adsorption. However, the lower R² values compared to Langmuir indicate that monolayer adsorption is the predominant mechanism. In conclusion, BC/CS/EGCG shows superior adsorption toward Pb²⁺, followed by Cu²⁺ and Fe³⁺, driven by the strong chelating ability of EGCG’s catechol and galloyl groups. These findings highlight the material’s strong potential for heavy metal ion removal in environmental applications.

Figure 11 Adsorption isotherms of Pb²⁺, Cu²⁺, and Fe³⁺ Ions onto BC/CS/EGCG composite film using Langmuir and Freundlich models.
Ion |
Model |
Linear Equation |
R² |
qmax (mg/g) |
KL (L/mg) |
KF |
n |
Pb²⁺ |
Langmuir |
1/qe = 0.9814 × (1/Ce) + 0.0371 |
0.9934 |
26.96 |
26.48 |
– |
– |
|
Freundlich |
log(qe) = 0.5705 × log(Ce) + 0.2914 |
0.9470 |
– |
– |
1.96 |
1.75 |
Cu²⁺ |
Langmuir |
1/qe = 1.1967 × (1/Ce) + 0.0421 |
0.9960 |
23.75 |
28.45 |
– |
– |
|
Freundlich |
log(qe) = 0.5924 × log(Ce) + 0.1907 |
0.9568 |
– |
– |
1.55 |
1.69 |
Fe³⁺ |
Langmuir |
1/qe = 1.0617 × (1/Ce) + 0.0408 |
0.9970 |
24.51 |
26.01 |
– |
– |
|
Freundlich |
log(qe) = 0.5787 × log(Ce) + 0.2443 |
0.9585 |
– |
– |
1.76 |
1.73 |
Evaluation of antibacterial ability of composite membranes
From Figure 12, it is evident that the BC/CS/EGCG composite films exhibit notable antibacterial activity against E. coli, with inhibition zones varying by EGCG concentration. Specifically, the inhibition zone diameters were approximately 18 mm for BC/CS/EGCG 0.3%, 16 mm for BC/CS/EGCG 0.4%, and 12 mm for BC/CS/EGCG 0.2%. The sample with 0.3% EGCG achieved the largest clear zone, suggesting optimal antibacterial efficacy at this concentration. While 0.4% EGCG also showed strong inhibition, the slight decrease in zone size could be due to over-saturation, which may impede uniform EGCG release or interaction with bacterial cells. The lower diameter at 0.2% EGCG reflects a threshold level of bioactivity. Overall, these results reinforce that a moderate EGCG loading (~0.3% w/v) yields the most effective balance between antibacterial activity and matrix integrity, making it a promising candidate for antimicrobial applications in food packaging and biomedical fields.
Based on Figure 13, the antibacterial efficiency of the composite films increases notably with EGCG incorporation. The inhibition zone diameters against S. aureus were approximately 24 mm for BC/CS/EGCG 0.3%, 20 mm for BC/CS/EGCG 0.4%, and 18 mm for BC/CS/EGCG 0.2%. These results suggest that the 0.3% EGCG concentration provides the most effective balance between sufficient diffusion of EGCG and structural compatibility with the BC/CS matrix. Although 0.4% EGCG still maintains strong antibacterial activity, the slight reduction in inhibition zone may result from polyphenol overloading, which can hinder uniform diffusion. The 0.2% EGCG film, while active, is less effective likely due to insufficient EGCG content to disrupt bacterial membranes robustly. Notably, films without EGCG showed negligible zones, affirming EGCG’s essential role in bacterial inhibition. This highlights the dose-dependent antibacterial enhancement imparted by EGCG and confirms the optimal EGCG loading around 0.3% w/v for practical antibacterial applications.
Antibacterial test results demonstrated that BC/CS/EGCG composite films exhibited significant inhibition against both E. coli and S. aureus, with the 0.3% EGCG film showing the largest inhibition zones (~18 mm for E. coli and ~24 mm for S. aureus). These findings are consistent with previous studies: for example, Steinmann et al. [24] reported that EGCG disrupts bacterial membranes and induces reactive oxygen species; Friedman [25] stated that the MIC values of EGCG are 50 - 125 µg/mL for S. aureus and 125 - 500 µg/mL for E. coli, confirming stronger activity against Gram-positive bacteria. At lower EGCG concentrations (0.2%), antibacterial activity was still observed but significantly reduced (~12 mm for E. coli), indicating a threshold below which efficacy diminishes. Conversely, at 0.4%, inhibition zones slightly decreased, possibly due to polyphenol aggregation hindering diffusion. Overall, the data suggest that 0.3% EGCG is the optimal concentration, achieving high antibacterial performance while maintaining structural compatibility with the BC/CS film matrix.
Figure 12 Antibacterial performance of BC/CS/EGCG composite films against E. coli using the agar diffusion method: (a) BC/CS/EGCG 0.3% - (b) BC/CS/EGCG 0.2% - (c) BC/CS/EGCG 0.4% - (d) CS/EGCG - (e) BC - (f) BC/EGCG
Figure 13 Antibacterial performance of various EGCG-loaded composite films against Staphylococcus aureus (SA).
Application orientation in pharmaceutical packaging
UV blocking ability (UV-Vis from 200 - 400 nm)
From Figure 14, it is evident that the EGCG-incorporated composite film (BC/CS/EGCG) exhibits superior ultraviolet (UV) absorption and shielding performance compared to individual BC and CS films. At the wavelength of 280 nm characteristic of polyphenol groups the BC/CS/EGCG film reaches the highest absorbance (~0.88 a.u.), while CS and BC only show around 0.42 and 0.28 a.u., respectively. Simultaneously, in the UV transmittance graph, the BC/CS/EGCG film shows a significant reduction in UV transmittance, dropping below 10% in both UVA and UVB regions, far outperforming the CS and BC films, which transmit 40% to 70% of UV light. These results confirm that EGCG not only enhances antibacterial activity but also plays a crucial role in improving optical properties, especially UV-blocking ability. With this feature, the BC/CS/EGCG film holds great potential for applications in food and pharmaceutical packaging, where UV protection is critical to maintaining product quality.

Figure 14 UV-Vis absorption and transmittance spectra of BC, CS, and BC/CS/EGCG composite films.
Table 3 UV absorption efficiency at 280 nm.
|
Based on the data from Tables 3 and 4, the BC/CS/EGCG composite film demonstrates superior UV absorption and blocking capabilities compared to pure BC or CS films. Specifically, at the wavelength of 280 nm, the BC film absorbs only about 28% of UV light, CS absorbs around 45%, while the BC/CS/EGCG film achieves a high absorption efficiency of approximately 81%. This enhanced performance is attributed to the presence of EGCG, whose polyphenolic structure enables strong absorption in the 273 to 330 nm range, effectively protecting the material from UV-induced photodegradation. The transmittance values at key UV wavelengths (230 to 375 nm) also indicate that BC/CS/EGCG films exhibit significantly better shielding against UV-C, UV-B, and UV-A radiation. For instance, at 300 nm, BC and CS films allow up to 85% and 70% transmittance, respectively, while the BC/CS/EGCG film reduces it to around 30%. These results confirm the comprehensive UV-blocking functionality of the EGCG-integrated composite film, highlighting its strong potential for applications in UV-protective packaging for food, pharmaceuticals, and biocompatible materials.
Table 4 % transmittance of composite films at key UV wavelengths.
Wavelength (nm) |
BC film |
CS film |
BC/CS/EGCG film |
Region |
230 |
~5% |
~10% |
~1% |
UV-C |
260 |
~40% |
~30% |
~10% |
UV-B |
280 |
~70% |
~55% |
~20% |
UV-B |
300 |
~85% |
~70% |
~30% |
UV-B/UVA |
320 |
~95% |
~85% |
~45% |
UVA |
350 |
~97% |
~90% |
~65% |
UVA |
375 |
~98% |
~95% |
~80% |
UVA |
Humidity and pH sensing capabilities
From Table 5 and Figure 15, the outstanding pH-sensing performance of the EGCG-integrated composite film is clearly demonstrated. The BC/CS/EGCG film exhibits a pronounced color change from yellow to brown/green as the pH increases from 3 to 11, whereas the BC and CS films show little to no visible changes. Notably, the absorbance at 510 nm significantly increases from approximately 0.13 to 0.48 a.u., indicating a strong sensitivity to environmental pH. The color transition is primarily attributed to mild oxidation of EGCG and molecular structural shifts driven by π π stacking interactions. These findings confirm EGCG’s central role in enabling pH responsiveness and highlight the composite film’s potential as an intelligent food packaging material that can visually monitor product quality and freshness through color changes.
Table 5 Color change response of films under humidity and pH conditions.
Film sample |
Color change in Humid/pH environment |
Reaction mechanism |
BC |
No visible change, slight moisture absorption |
No inherent color indicator |
CS |
Slight yellowing in alkaline conditions |
Due to protonation/deprotonation of amine groups |
BC/CS/EGCG |
Clear color change from yellow → brown/green |
Mild oxidation of EGCG and π π stacking structure shift |

Figure 15 Color change behavior of films under varying pH (Absorbance at 510 nm).
Effect on the stability of the hypothetical drug sample (paracetamol tablets)
Based on Table 6: Stability After 14 Days at 75% Relative Humidity, the BC/CS/EGCG composite film demonstrates excellent protective capacity for paracetamol tablets, showing only ~3.7% mass loss after 14 days. The tablets maintained their shape, structural integrity, and color, indicating superior moisture resistance and effective shielding against humidity-induced degradation. In contrast, tablets wrapped with pure BC suffered significant damage, with a ~21% mass loss, softening, and noticeable discoloration, highlighting BC’s poor moisture barrier due to its transparent and hydrophilic structure. Chitosan (CS) provided partial protection with ~12% mass loss, but it was not sufficient to fully prevent tablet degradation. These findings clearly emphasize that the integration of EGCG into the BC/CS matrix not only enhances film strength but significantly improves protection under high-humidity conditions. This makes the BC/CS/EGCG composite a promising candidate for pharmaceutical packaging, especially in environments with elevated relative humidity.
Tablet 6 Stability after 14 days at 75% relative humidity.
Film sample |
Tablet mass loss (%) |
Observed drug degradation |
BC |
~21% |
Tablets absorbed moisture, became soft, and changed color. |
CS |
~12% |
Provided partial protection, but not sufficient. |
BC/CS/EGCG |
~3.7% |
Tablets retained mass and shape → excellent protection. |
Structural and Interaction Effects of EGCG in BC/CS Composite Films: Insights from FTIR, UV Vis, and XRD Analyses
Figure 16 presents a set of structural and interaction analyses of BC/CS composite films integrated with green tea extract using FTIR, UV-Vis, and XRD techniques. The FTIR spectrum (Figure 6(a)) shows a characteristic absorption peak at ~1,730 cm⁻¹, attributed to the C=O stretching vibration, which is more prominent in the EGCG-containing sample. This indicates the formation of hydrogen bonds between –OH and –NH₂ groups in the polymer matrix and the polyphenols from the extract. The reduced transmittance in the BC/CS/EGCG sample further confirms strong interaction and enhanced infrared absorption. The molecular schematic (Figure 6(b)) illustrates the potential formation of ester linkages, π–π stacking interactions, and hydrogen bonding between EGCG hydroxyl groups and the cellulose or chitosan matrix, contributing to structural stability. The UV-Vis spectrum (Figure 6(c)) reveals a strong absorption peak at ~395 nm in the green tea sample, significantly higher than in the BC and CS films, confirming that the optical activity of EGCG is preserved and contributes to the film’s UV shielding capability. XRD analysis (Figure 6(d)) shows a substantial reduction in crystalline peak intensity at 2θ ≈ 20 to 23 in EGCG-integrated films, indicating a shift toward a semi-amorphous structure, which may enhance flexibility and permeability. Based on these analyses, it can be preliminarily concluded that EGCG functions not only as a bioactive compound but also as a network-interacting agent that alters the structure and improves the optical, mechanical, and chemical performance of the composite. Future research may focus on evaluating the influence of EGCG concentration on the degree of amorphousness, release behavior, metal adsorption performance, and validation through molecular simulation.

Figure 16 Structural and interaction characterization of BC/CS films integrated with green tea extract using FTIR, UV-Vis, and XRD analyses.
Conclusions
The incorporation of a small amount of green tea-derived EGCG into bacterial cellulose/chitosan matrices significantly improved the performance of the resulting biocomposite films across mechanical, thermal, optical, and bioactive domains. The optimal formulation containing 0.3% EGCG exhibited a tensile strength of 43 MPa, enhanced thermal resistance (onset at ~300 C), and excellent UV-shielding capacity. The film also demonstrated strong pH-responsive colorimetric changes and highly selective adsorption of heavy metal ions, with a Pb²⁺ capacity of up to 26.96 mg/g and a detection limit of 0.70 µM. Antibacterial testing confirmed the effectiveness of the film against E. coli and S. aureus, while drug protection trials validated its superior humidity resistance.
These findings confirm that EGCG not only functions as an active antioxidant and antibacterial agent but also as a structural enhancer and optical sensor within the biopolymer matrix. This work highlights the promising application prospects of BC/CS/EGCG films in:
Intelligent food packaging with real-time freshness monitoring,
Pharmaceutical packaging for moisture-sensitive drugs,
Environmental sensing and remediation, especially for detecting and removing heavy metal ions.
The results lay a foundation for future developments in green, multifunctional, and biodegradable packaging materials, offering a sustainable alternative to synthetic plastics in high-performance applications.
Acknowledgements
The authors wish to thank the Faculty of Chemical Technology, Hanoi University of Industry (HaUI), Vietnam for supporting this work.
Declaration of generative AI in scientific writing
Declaration of Generative AI in Scientific Writing
This manuscript utilized generative AI tools, namely ChatGPT (OpenAI) and Grammarly, to enhance language clarity, grammar, and overall readability.
• All AI-assisted edits were made under strict human oversight and control.
• These tools were not used to:
• Generate scientific content
• Interpret or analyze data
• Develop research questions
• Draw or formulate conclusions
The authors affirm that they are fully responsible for the intellectual content, scientific accuracy, and integrity of this manuscript.
CRediT author statement
Tuan Anh Nguyen: Conceptualization, Methodology, Supervision, Writing – Original Draft, Project Administration, Funding Acquisition.
Thi Hanh Do: Data Curation, Investigation, Validation, Writing – Review & Editing.
Thi Dung Ha: Formal Analysis, Resources, Visualization, Writing – Review & Editing.
References
[1] X Chen, X Ding, Y Huang, Y Zhao, G Chen, X Xu, D Xu, B Jiao, X Zhao and G Liu. Recent advances in polysaccharide-based nanocomposite films for fruit preservation: Construction, applications, and challenges. Foods 2025; 14(6), 1012.
[2.] R Priyadarshi, A Jayakumar, CK de Souza, JW Rhim and JT Kim. Advances in strawberry postharvest preservation and packaging: A comprehensive review. Comprehensive Reviews in Food Science and Food Safety 2024; 23(4), e13417.
[3] M Su, F Liu, T Abdiryim and X Liu. Polysaccharides and their derivatives for solar-driven water evaporators. Cellulose 2024; 31(12), 7251.
[4] X Cai, L Chen, X Yang, Y Wang, J Xu, R Zhang, S Ling and Y Liu. Active curcumin-loaded γ-cy.clodextrin-metal organic frameworks as nano respiratory channels for reinforcing chitosan/gelatin films in strawberry preservation. Food Hydrocolloids 2024; 159(5), 110656.
[5] Y Li, B Bian, R Tang and K Zhang. Characterization of a clove essential oil slow-release microencapsulated composite film and its preservation effects on blueberry. ACS Omega 2024; 9(11), 12643.
[6] T Li, C Chen, AH Brozena, JY Zhu, L Xu, C Driemeier, J Dai, OJ Rojas, A Isogai, L Wågberg and L Hu. Developing fibrillated cellulose as a sustainable technological material. Nature 2021; 590(7844), 47-56.
[7] M Abdelraof, MS Hasanin, MM Farag and HY Ahmed. Green synthesis of bacterial cellulose/bioactive glass nanocomposites: Effect of glass nanoparticles on cellulose yield, biocompatibility and antimicrobial activity. Int. J. Biol. Macromol. 2019; 138, 975-985.
[8] M Aliabadi, BS Chee, M Matos, YJ Cortese, MJD Nugent, TAMD Lima, WLE Magalhães and GGD Lima. Yerba mate extract in microfibrillated cellulose and corn starch films as a potential wound healing bandage. Polymers 2020; 12(12), 2807.
[9] RSCMDQ Antonino, BRPL Fook, VADO Lima, RÍDF Rached, EPN Lima, RJDS Lima, CAP Covas and MVL Fook. Preparation and characterization of chitosan obtained from shells of shrimp (Litopenaeus vannamei Boone). Marine Drugs 2017; 15(5), 141.
[10] FS Jebel, L Roufegarinejad, A Alizadeh and S Amjadi. Development and characterization of a double-layer smart packaging system consisting of polyvinyl alcohol electrospun nanofibers and gelatin film for fish fillet. Food Chemistry 2025; 462, 140985.
[11] Z Miao, M Yang, SYH Abdalkarim and HY Yu. In situ growth of curcumin-loaded cellulose composite film for real-time monitoring of food freshness in smart packaging. International Journal of Biological Macromolecules 2024; 279(P1), 135090.
[12] W Zhang, M Li, J Chen, Y Chen, C Liu and X Wu. A review of modified gelatin: Physicochemi cal properties, modification methods, and applications in the food field. Journal of Agricultural and Food Chemistry 2024; 72(38), 20705.
[13] QB Yao, F Huang, YH Lu, JM Huang, M Ali, XZ Jia, X Zeng and YY Huang. Polysaccharide-based food packaging and intelligent packaging applications: A comprehensive review. Trends in Food Science & Technology 2024; 147, 104390.
[14] T Sarwar, ZA Raza, MA Nazeer and A Khan. Synthesis of aminolyzed gelatin-mediated chitosan as pH-responsive drug-carrying porous scaffolds. International Journal of Biological Macromolecules 2024; 256(P2), 128525.
[15] C Phaenark, T Jantrasakul, P Paejaroen, S Chunchob and W Sawangproh. Sugarcane bagasse and corn stalk biomass as a potential sorbent for the removal of Pb(II) and Cd(II) from aqueous solutions. Trends in Sciences 2022; 20(2), 6221.
[16] E Melro, FE Antunes, GJD Silva, I Cruz, PE Ramos, F Carvalho and L Alves. Chitosan films in food applications. Tuning film properties by changing acidic dissolution conditions. Polymers 2021; 13(1), 1.
[17] Indriyati, F Dara, I Primadona, Y Srikandace and M Karina. Development of bacterial cellulose/chitosan films: Structural, physicochemical and antimicrobial properties. Journal of Polymer Research 2021; 28(3), 02328.
[18] Y Xu, X Liu, Q Jiang, D Yu, Y Xu, B Wang and W Xia. Development and properties of bacterial cellulose, curcumin, and chitosan composite biodegradable films for active packaging materials. Carbohydrate Polymers 2021; 260(2), 117778.
[19] MA Ghamari, S Amiri, M Rezazadeh-Bari and L Rezazad-Bari. Physical, mechanical, and antimicrobial properties of active edible film based on milk proteins incorporated with Nigella sativa essential oil. Polymer Bulletin 2022; 79, 1097.
[20] B Wang, Y Dan, H Zhang, C Huang, L Xiong, J Luo and XD Chen. Preparation of esterified bacterial cellulose for improved mechanical properties and the microstructure of isotactic polypropylene/bacterial cellulose composites. Polymers 2016; 8(4), 129.
[21] YB Azaza, M Hamdi, C Charmette, AVD Lee, M Jridi, S Li, M Nasri and R Nasri. Development and characterization of composite films based on chitosan and collagenous proteins from bluefin tuna: Application for peeled shrimp preservation. Cellulose 2023; 30, 373-395.
[22] C Cabrera, R Artacho and R Giménez. Beneficial effects of green tea - A review. Journal of the American College of Nutrition 2006; 25(2), 79-99.
[23] QV Vuong, JB Golding, M Nguyen and PD Roach. The impact of aqueous extraction conditions on the phenolic content and antioxidant activities of green tea extract. LWT-Food Science Technology 2011; 44, 1328.
[24] J Steinmann, J Buer, T Pietschmann and E Steinmann. Anti-infective properties of epigallocatechin-3-gallate (EGCG), a component of green tea. British Journal of Pharmacology 2013; 168(5), 1059-1073.
[25] M Friedman. Antibacterial, antiviral, and antifungal properties of green tea catechins. Journal of Food Protection 2007; 70, 2223.